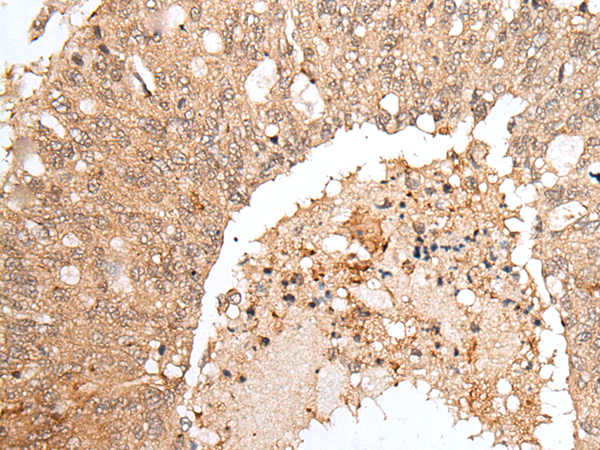
一抗

中文名稱: 兔抗HOXB9多克隆抗體
英文名稱: Anti-HOXB9 rabbit polyclonal antibody
別 名: HOX2; HOX2E; HOX-2.5
相關類別: 一抗
儲 存: 冷凍(-20℃)
宿 主: Rabbit
標 記 物: Unconjugate
克隆類型: Unconjugate
技術規格
|
Background: |
This gene is a member of the Abd-B homeobox family and encodes a protein with a homeobox DNA-binding domain. It is included in a cluster of homeobox B genes located on chromosome 17. The encoded nuclear protein functions as a sequence-specific transcription factor that is involved in cell proliferation and differentiation. Increased expression of this gene is associated with some cases of leukemia, prostate cancer and lung cancer. |
|
Applications: |
ELISA, IHC |
|
Name of antibody: |
HOXB9 |
|
Immunogen: |
Synthetic peptide of human HOXB9 |
|
Full name: |
homeobox B9 |
|
Synonyms: |
HOX2; HOX2E; HOX-2.5 |
|
SwissProt: |
P17482 |
|
ELISA Recommended dilution: |
5000-10000 |
|
IHC positive control: |
Human colorectal cancer and human tonsil |
|
IHC Recommend dilution: |
25-100 |




 購物車
購物車 幫助
幫助
 021-54845833/15800441009
021-54845833/15800441009